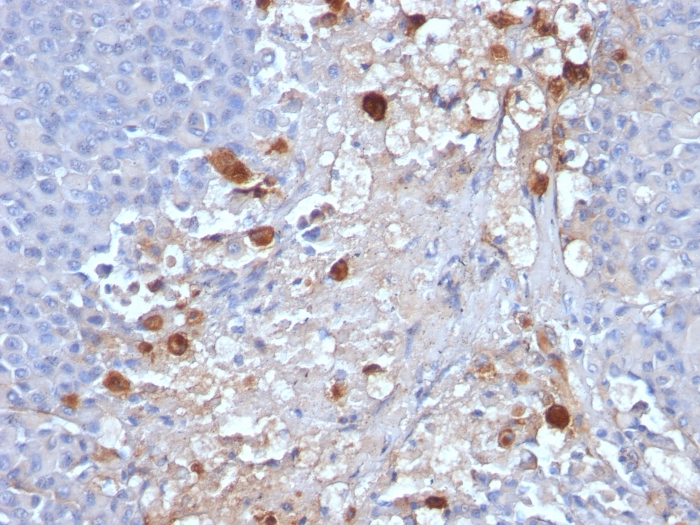

Formalin-fixed, paraffin-embedded human Melanoma stained with MCAM Mouse Monoclonal Antibody (MCAM/1101).

Formalin-fixed, paraffin-embedded human Melanoma stained with MCAM Mouse Monoclonal Antibody (MCAM/1101).
The human Mel-CAM gene maps to chromosome 11q23 and encodes a trans-membrane glycoprotein, also designated MCAM, MUC 18 or CD146, that belongs to the immunoglobulin superfamily and functions as a Ca2+-independent cell adhesion molecule. Mel-CAM expression is restricted to advanced primary and metastatic melanomas and to cell lines of the neuroectodermal lineage, but not normal melanocytes. Mel-CAM is found on 80% of advanced primary human melanomas and correlates well with development of metastatic disease.
There are no reviews yet.